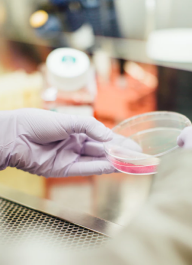

MediCare
Kami Peduli Terhadap
Kesehatan Anda
Dapatkan Layanan Medis yang Nyaman dan Terpercaya, Fasilitas Lengkap, Konsultasi dan Dokter jaga 24 Jam
Dipercaya 6309+
Dokter, perawat, psikiater dan tenaga ahli medis lainnya

Dok. Thiago

Dok. Evelyn

Alexander

Edward